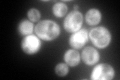
YGR264C
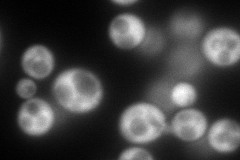
YGR264C
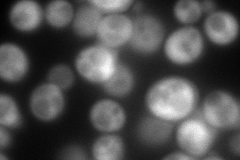
YGR264C
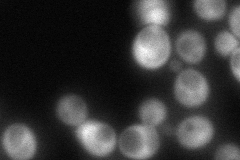
YGR264C
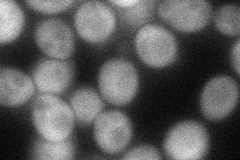
YGR264C
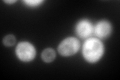
YGR264C
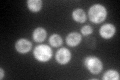
YGR264C

View description
Methionyl-tRNA synthetase, forms a complex with glutamyl-tRNA synthetase (Gus1p) and Arc1p, which increases the catalytic efficiency of both tRNA synthetases; also has a role in nuclear export of tRNAs
Localization:
Intensity:
Fold change:
Significance:
-
C’ GFP library in SD
cytosol217.8 -
N' NOP1pr-GFP in SD
cytosol235.678 -
N' TEF2pr-mCherry in SD
cytosol226.147 -
N' NATIVEpr-GFP in SD
cytosol95.7414 -
N' TEF2pr-VC and Cyto-VN in SD
cytosol70.2435 -
C’ GFP library in SD+DTT
cytosol263.211.2No -
C’ GFP library in SD+H2O2

cytosol266.71.22No -
C’ GFP library in Starvation Media
cytosol161.920.74No -
C’ GFP library on the background of Pup2-DaMP

cytosol -
C’ GFP library on the background of CCT mutant

cytosol275.0591.26284No
